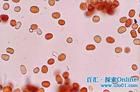
紅雨

旋轉火焰-簡介
旋轉火焰形成於森林火災的強烈熱量並夾帶著火焰,在地面生成像龍捲風的一股火焰,侵襲它到達的區域。
 旋轉火焰
旋轉火焰旋轉火焰是森林火災過程中的特殊火行為現象。它給火災的救指標工作帶來難度,給撲火人員的人身安全帶來了嚴重的危害。火旋風存在一種中空燃燒的狀態。通過燃燒風洞,對不同來流影響下的火旋風進行分析研究。通過一個置於大型燃燒風洞中的邊角開有切向進風口的六邊形小尺寸火旋風發生模型,套用熱電偶測溫和皮托管測速以及電子數據採集系統,對該模型內的溫度分布數據和速度分布數據進行採集。通過燃燒風洞改變來流速度的大小,分析不同來流速度下火旋風內部的溫度分布、速度分布和持續時間,研究來流速度對火旋風內部燃燒結構的影響、火旋風旋轉速度的影響以及持續時間的影響。
研究表明:來流改變了火旋風內部的燃燒結構,促進了中空燃燒狀態的形成。中空燃燒狀態有一個中心的低溫區域。在中心低溫區域溫度最低時,火旋風持續時間最長。來流增強了火旋風的整體轉動,並且加劇了火旋風的螺旋狀上升。火旋風最高火焰可達4米,不過其威力足以將一棵小樹連根拔起,可見其威力之大。
旋轉火焰-研究
地球是人類賴以生存的家園,它賦予我們的不僅僅是豐足的食物和居住的空間,奇特的自然現象也能帶來美的享受,同事也引發對破壞自然行為的反思。
通過磁場對旋轉火焰特性影響的研究,發現磁場能夠改變旋轉火焰的燃燒特性和燃燒規律,使火焰的溫度和高度都會發生一定程度的變化。因此,可以更準確地了解實際火災過程中火旋風的燃燒特性,掌握實際火災中火焰的燃燒特點,當實際火災發生並產生火旋風時,了解地球磁場的存在對實際的火旋風的影響程度,從而根據其燃燒的規律性,採取有效的措施,控制火旋風的發展。
自然界裡罕見的自然現象
| 自然界中由於大自然的運作規律自發形成的的某種狀況,其完全不受人為主觀能動性因素影響。如月有陰晴圓缺,四季變化,氣候的冷暖,颳風下雨,白天黑夜等。主要有物理現象﹑地理現象﹑化學現象等幾大類。相對於由人類引發的社會現象而言。 |
自然界罕見的現象
| 簡介 | 地球上有許多自然現象仍是一個謎團,科學家尚無法準確解釋其間的神秘,同時這些奇特的自然現象卻極具魅力,釋放出地球大自然所獨有的絢麗。 |
| 雲 | 乳狀雲| 重力波雲層| 重力波雲| 雨幡洞雲| 滾軸雲| 莢狀高積雲| 帽子云| 波浪雲| 幡狀雲| 浪花雲| 馬蹄狀漩渦雲| 陣晨風雲| 開爾文-赫姆霍茲波浪| 穿洞雲| 飛碟雲| 魚鱗雲| 地震雲| 夜光雲| 莢狀高積雲| 流火雲 |
| 彩虹 | 雪茄狀彩虹| 火彩虹| 月虹| 雙重彩虹| 霧虹| 火彩虹| 午夜彩虹| 布洛肯彩虹 |
| 月亮 | 月徑幻覺| 半影月食| 月全食| 月偏食| 月食| 月亮蜃景| 半影月食| 藍月亮| 月掩金星| 月掩星| 紅月亮 |
| 雷電 | 聖艾爾摩之火| 超級閃電| 球形閃電| 反向閃電| 黑色閃電| 枝狀閃電| 閃電森林| 彩色閃電 |
| 星系 | 草帽星系| 黑眼星系| 雙胞胎星系| 渦狀星系| 大螺旋星系| 超新星1987A| 棒旋星系| 哈氏天體| M81星系| 星系NGC 3370| 金火合月| 船尾座流星雨| 英仙座流星雨| 天琴座流星雨| 天龍座流星雨| 金牛座流星雨| 獵戶座流星雨|雙子座流星雨| 獅子座流星雨| 金星凌日| 海爾-波普彗星| 水星凌日| 鹿林彗星| 恆星工廠| 四星凌土| 金火合月| 天琴座流星雨| 船尾座流星雨| 水星東大距| 雙星伴月|英仙座流星雨| 寶瓶座流星雨 |
| 雨雪 | 冰圈| 雨凇| 霧凇| 凍雨| 雪暴| 冰錐群| 紅雨| 光線雨 |
| 光 | 鬼影 |
| 火光 | 旋轉火焰| 極光| 北極光| 天使頭髮 |
| 海水 | 魚雨| 赤潮| 拉尼娜 |